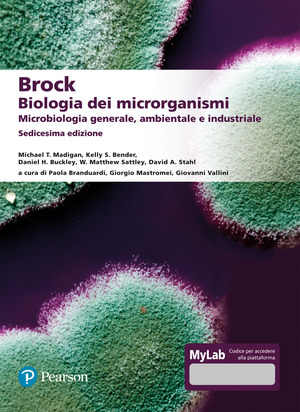
Brock. Biologia dei microrganismi. Microbiologia generale, ambientale e industriale. Ediz. Mylab. Con aggiornamento online

Disponibilità
Disponibilità immediata
Articolo immediatamente disponibile in libreria per il prenota e ritira. In caso di consegna a domicilio, spedizione entro un giorno lavorativo.
Nota: la disponibilità fa riferimento alla singola unità.
Disponibile in 3/4 giorni
L’articolo non è al momento disponibile in libreria. La disponibilità è espressa in base alle informazioni comunicate dal fornitore. Per le librerie che si trovano sulle isole i tempi di arrivo dei titoli ordinati potrebbero essere superiori rispetto a quanto indicato. Qualora il prodotto non fosse disponibile, verrai avvisato via e-mail entro il termine suddetto; ti ricordiamo che l’addebito avviene solo al momento della spedizione (vedi art.5 delle Condizioni Generali di Vendita).
Disponibile in 5 giorni
L’articolo non è al momento disponibile in libreria. La disponibilità è espressa in base alle informazioni comunicate dal fornitore. Per le librerie che si trovano sulle isole i tempi di arrivo dei titoli ordinati potrebbero essere superiori rispetto a quanto indicato. Qualora il prodotto non fosse disponibile, verrai avvisato via e-mail entro il termine suddetto; ti ricordiamo che l’addebito avviene solo al momento della spedizione (vedi art.5 delle Condizioni Generali di Vendita).
Disponibile in 7 giorni
L’articolo non è disponibile al momento in libreria. La disponibilità è espressa in base alle informazioni comunicate dal fornitore. Possiamo stamparlo per te e procurartelo in 7 giorni lavorativi! Per le librerie che si trovano sulle isole i tempi di arrivo dei titoli ordinati potrebbero essere superiori rispetto a quanto indicato.
Difficile reperibilità
L’articolo non è disponibile al momento ed è estremamente difficile reperirlo. Se vuoi comunque procedere con l’ordine, il libraio si impegnerà a cercarlo per te e ad avvisarti in merito alla ricerca. In caso di consegna a domicilio, ti ricordiamo che l’addebito avviene solo al momento della spedizione (vedi art.5 delle Condizioni Generali di Vendita).
Attualmente non disponibile
L’articolo non è disponibile al momento. La disponibilità è espressa in base alle informazioni comunicate dal fornitore. Qualora il prodotto non fosse disponibile, verrai avvisato via e-mail entro il termine suddetto; ti ricordiamo che l’addebito avviene solo al momento della spedizione (vedi art.5 delle Condizioni Generali di Vendita) Non ordinabile L’articolo non è disponibile al momento. La disponibilità è espressa in base alle informazioni comunicate dal fornitore. Se vuoi essere avvisato se e quando l’articolo torna disponibile, puoi lasciarci la tua email e sarà cura del libraio contattarti tempestivamente.
Non ordinabile
L’articolo non è disponibile al momento. La disponibilità è espressa in base alle informazioni comunicate dal fornitore.
Se vuoi essere avvisato se e quando l’articolo torna disponibile, puoi lasciarci la tua email e sarà cura del libraio contattarti tempestivamente.
In arrivo
L’articolo è di prossima pubblicazione. La disponibilità è espressa in base alle informazioni comunicate dal fornitore. Se vuoi essere avvisato quando l’articolo diventa disponibile, puoi lasciarci la tua email e verrai avvisato tempestivamente.
Nuova versione disponibile
L’articolo che hai scelto non è disponibile al momento, ma esiste una nuova edizione disponibile. La disponibilità è espressa in base alle informazioni comunicate dal fornitore. Dalla scheda libro puoi andare alla nuova versione.